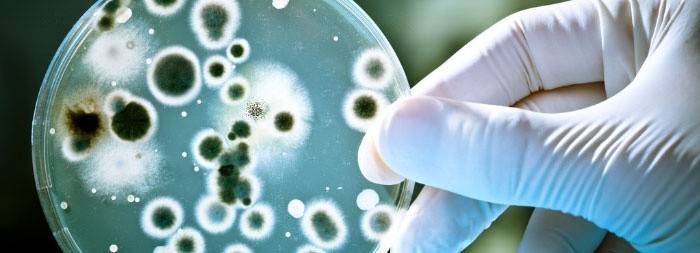

Como e como tratar Gardnerella em mulheres
Muitas doenças nos esperam em um momento em que a imunidade é enfraquecida devido a alguns fatores. Uma doença chamada gardnerella nas mulheres ocorre como resultado da formação de um desequilíbrio na microflora vaginal. Antes de prescrever o tratamento, você precisa estabelecer a causa da doença. Em quase todos os casos, Gardnerella aparece devido a um número insuficiente de lactobacilos que fornecem microflora normal na vagina feminina. Quão perigosa é esta doença para as mulheres, especialmente durante a gravidez, e como tratá-la?
O que é gardnerella?
A vaginalise bacteriana ou Gardnerella é uma das doenças comuns que ocorrem nas mulheres. Inicialmente, acreditava-se que sua transmissão era realizada exclusivamente por contato sexual. Mas logo foi possível estabelecer que inicialmente na microflora há certo número de micróbios patogenéticos que podem provocar o desenvolvimento de gardnerella em uma mulher.
A presença do microrganismo Gardnerella em todas as mulheres saudáveis é a norma. Os lactobacilos impedem a multiplicação dessas bactérias patogênicas e garantem a manutenção do ambiente interno correto da vagina, produzindo ácido lático. A lactoflora atua como um sistema protetor local, ajudando a suprimir o crescimento de bactérias, prevenindo o aparecimento do desenvolvimento da doença.
As principais razões para o aparecimento de gardnerella são uma diminuição acentuada no número de lactobacilos sob certas circunstâncias e o início de um aumento rápido e ativo do número de bactérias anaeróbias. Como resultado, o ambiente vaginal da mulher torna-se alcalino e existe uma grande oportunidade para várias infecções entrarem. Portanto, gardnerella em quase todos os casos é complicada pelo aparecimento de doenças inflamatórias associadas ao sistema geniturinário.
Sintomas e sinais da doença
O ataque do desenvolvimento em mulheres de gardnerella não se acompanha pelos sinais mais agradáveis:
- Quando infectado com gardnerella, aparece corrimento vaginal abundante, com tonalidade acinzentada, amarelada ou esverdeada. Mas eles podem ser completamente transparentes, se uma mulher foi capaz de perceber o desenvolvimento da doença no início. Descargas com gardnerella têm uma consistência uniforme (espuma ou cremosa).
- A infecção provoca o aparecimento de uma forte sensação de desconforto na vagina - comichão, ardor, sensações dolorosas na região dos lábios externos estão preocupados.
- Com Gardnerella, as mulheres experimentam dor no períneo.
- Os lábios podem ficar vermelhos, inchados.
- Durante a proximidade, na presença de Gardnerella, dor, ardor, coceira aparece. Como resultado de relações sexuais com um parceiro infectado, um homem pode ser infectado.
- O corrimento vaginal com gardnerella tem um odor desagradável característico, reminiscente do fedor de peixe podre.

Métodos diagnósticos
Se pelo menos um dos sinais acima de gardnerella for encontrado, uma mulher precisa ser examinada por um ginecologista, especialmente ao planejar a gravidez. Para determinar a doença, o médico faz um exame. Este é um método comum e mais preciso para diagnosticar a Gardnerelose. Com a ajuda de um microscópio, é fácil examinar células de esfregaço, nas quais existe uma camada espessa de Gardnerella. Um método também está sendo conduzido para determinar o nível de pH do ambiente vaginal. Em condições normais, a vagina tem um ambiente ácido e, como resultado do crescimento patológico de gardnerella, muda para alcalina.
Graças à reação ao isonitrilo (uma substância que dá ao corrimento vaginal um odor desagradável característico de peixe podre), uma confirmação final do diagnóstico correto torna-se possível. Às vezes, se houver suspeita de gardnerella, uma mulher recebe um exame de sangue para determinar o nível de glóbulos brancos, mas isso não é necessário.
Assim que a presença da doença é determinada com precisão, o médico prescreve que o paciente faça testes adicionais para determinar as infecções do aparelho geniturinário que acompanham a Gardnerella. Um exame da mucosa vaginal e colo do útero é prescrito usando um dispositivo óptico especial no final do qual é uma lâmpada (colposcopia).

Gardnerella durante a gravidez - vale a pena temer?
A gravidez é um grande estresse para todo o corpo de uma mulher, porque, como resultado de um forte surto hormonal, as defesas do corpo são reduzidas. Durante esse período, o risco de desenvolver gardnerella aumenta várias vezes. O que é perigoso e quais as consequências que esta doença pode manifestar durante a gravidez, aprenda com o seguinte vídeo:
 Ureaplasma e Gardnerella. Estou planejando uma gravidez, o que devo fazer agora?
Ureaplasma e Gardnerella. Estou planejando uma gravidez, o que devo fazer agora?
Como tratar a Gardnerelose em mulheres
Para evitar as conseqüências negativas desta doença, é necessário um tratamento adequado para interromper completamente o crescimento patológico da Gardnerella no corpo feminino. Portanto, um regime de tratamento é prescrito com base na terapia antibacteriana, na qual o ureaplasma (o agente causador das infecções genitais) também é eliminado. Para mais detalhes sobre o tratamento de mulheres com Gardnerelose, veja o vídeo abaixo:
 Gel Metrogil para o tratamento da vaginose bacteriana
Gel Metrogil para o tratamento da vaginose bacteriana
Medicamentos
Em quase todos os métodos de tratamento de Gardnerella, o paciente toma clindamicina ou metronidazol.O tratamento local executa-se - supositórios vaginais (supositórios), unguentos, as pastilhas denominam-se às vezes injeções intravenosas. A duração do tratamento é de 7 a 10 dias. Somente o médico assistente determina a dosagem desejada do medicamento, levando em consideração os dados de análise obtidos e o grau de negligência do cultivar, peso corporal e idade do paciente, características individuais do corpo feminino.
Após 10 dias, a próxima etapa do tratamento é realizada, que é baseada no assentamento da vagina com microflora benéfica (bifido e lactobacilos). Para este propósito, não apenas a administração oral de probióticos é prescrita, mas também o uso local de supositórios vaginais. Antes do tratamento, um estudo de controle da vagina será realizado, durante o qual o crescimento da Gardnerella é interrompido (neste momento o seu número deve cair para o nível normal).
Remédios populares
O tratamento com Gardnerella é realizado com a ajuda de agentes que têm um efeito antibacteriano. Na medicina popular, um grande número de plantas medicinais é amplamente utilizado para esse fim. Aqui estão algumas maneiras eficazes:
- Douching usando infusões de erva de São João, camomila de farmácia, sálvia. Em um copo de água fervente, produzimos matérias-primas secas (2 colheres de sopa. Colheres de sopa).
- Ingestão interna de infusão de brotos de pinheiro. Despeje água fervente (500 g) em uma garrafa térmica e adicione os botões de pinheiro picados e secos (1 colher de sopa. Colher), deixe durante a noite. De manhã, passe a mistura por uma peneira e tome 4 vezes ao dia em uma forma morna, 0,5 xícaras (meia hora antes da refeição). O curso completo do tratamento dura exatamente 14 dias.
- O óleo da árvore do chá não só pode ser tomado por via oral, mas também aplicado topicamente. Em uma colher de sopa de leite, dissolva 1 gota de óleo e tome 2 vezes ao longo do dia. O curso completo do tratamento dura 3 semanas.
- Para aplicação tópica de óleo de melaleuca, fazemos uma solução: 5 gotas de óleo são dissolvidas em 10 g de qualquer óleo vegetal cozido. Na mistura resultante, umedecemos os cotonetes limpos, inserimos na vagina, deixamos durante a noite, removemos pela manhã. Tais procedimentos de tratamento devem ser realizados em dias alternados (10-11 procedimentos).
Prevenção de doenças
É necessário atacar o fortalecimento da imunidade, porque seu enfraquecimento provoca o início do desenvolvimento da Gardnerella de uma mulher. Em primeiro lugar, isso se refere à manutenção de um estilo de vida saudável e saudável. É necessário eliminar completamente o uso de álcool, deixar de fumar, evitar situações estressantes, comer direito, aprender a alternar o trabalho e o resto.
Passeios regulares no ar puro, o exercício nos esportes perfeitamente fortalece a imunidade, recomenda-se começar a temperar. É importante não permitir hipotermia severa do corpo e não esquecer a higiene íntima. Particular atenção deve ser dada à prevenção não só de gardnerella, mas também uma variedade de doenças sexualmente transmissíveis, infecções sexualmente transmissíveis.
Mudança freqüente de parceiro sexual, relacionamentos erráticos podem levar ao desenvolvimento de gardnerella em mulheres e homens. Você não pode usar douching, especialmente como medida de higiene pessoal. Isso pode levar a uma violação da microflora normal da vagina, uma diminuição da função protetora local da membrana mucosa, o que contribui para a multiplicação da Gardnerella. Não abuse de antibióticos porque, devido à ingestão descontrolada, o equilíbrio de microrganismos nocivos e benéficos nos intestinos e na vagina é perturbado.
